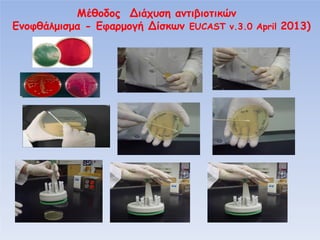
φ

μ μα -

φα μ

Β

υ
Βί

α
EUCAST v.3.0 April 2013)

More Related Content
PDF
7 φαινοτυπικές δοκιμασίες μηχανισμών αντοχής σε gram αρνητικά PPTX
ασφαλεσ διαδικτυο ηλιοδωρα βασια PPTX
κοινωνιολογία γ΄γενικού λυκείου PPTX
PPTX
PPTX
PPTX
PPT
Similar to 5 διαδικασίες προσαρμογής στο eucast
PPTX
PPT
PPT
PDF
Septicemia from NOVC_From the ER to the Lab.pdf PPTX
ΜΙΚΡΟΒΙΟΛΟΓΙΚΕΣ ΜΕΘΟΔΟΙ ΔΙΑΓΝΩΣΗΣ PDF
9 αλγόριθμοι ανίχνευσης αντοχής σε gram θετικά PPT
ΤΑ GOLD STANDARD ΤΗΣ ΕΡΓΑΣΤΗΡΙΑΚΗΣ ΔΙΑΓΝΩΣΗΣ ΣΤΙΣ ΒΑΚΤΗΡΙΑΚΕΣ ΛΟΙΜΩΞΕΙΣ PPTX
Ορθολογική Χρήση Αντιβιοτικών στην Κοινότητα-Συχνά Λάθη: .pptx PDF
PPT
PPTX
θεραπεία βακτηριακής μηνιγγίτιδας PPT
αντιμικροβιακα και αντιμυκητιασικα φαρμακα PDF
2 clsi & eucast. κριτήρια αξιολόγησης PDF
4 ερμηνευτικά κριτήρια σε gram αρνητικά βακτήρια PDF
8 αλγόριθμοι ανίχνευσης αντοχής σε gram αρνητικά 5 διαδικασίες προσαρμογής στο eucast
- 1.
- 2.
- 3.
π
α
α μ
υ πα
υα
π
υπα
μμα
μ
α
μα α
(
1.
παί
2.
υ
- α
α
πα
3. Β
- π
α
(
υ
Ο
μα
υ
μ ία)
α
π
μ
α
π
αφ
ία
μ
)
- 4.
- 5.
- 6.
Βα
α ί
πίπ
α μ
3.Β α φ
α
υ
υ α
μμα
π
υ
, -NAD
απ
μ
HB, ί
α
-panels αυ μα
μ α μ
4.
μ
μ
απ
α μα
ί Eucast
α α
υα
α μ
Eucast
ί υ
α
α
αυ μα υ
ί μ
- 7.
Βα
α ί
πίπ
5. Έ
α
ία
Ο α α
υ ία, α α
φ
μ
6. Έ
7. Έ
π
α μ
αφ
ίμ
Eucast
ί υ
α
π
,
- α α
υ
μ
αφ
McFarland
μ
Laboratory Information System LIS
- 8.
- 9.
- 10.
Β
υ
α
Θ
Mueller Hinton
Enterobacteriaceae
α (Eucast)
π
MuellerHinton -F
Streptococcus groups A,B,C,G
S. pneumoniae
Pseudomonas spp.
S. maltophilia
Acinetobacter spp.
Viridans streptococci
Haemophilus spp.
Moraxella catarrhalis
Staphylococcus spp.
L.monocytogenes
Enterococcus spp.
P. multocida
Campylobacter jejuni/coli
Other fastidious organisms
- 11.
Β
1
α α
2
υ
μ
υ
α
α α
υΘ π
(EUCAST version 3.0 April 2013)
5
μ
α
Έ
υ
π ί
μα
6
π
α μ
ί
υ α α
υα
Θ : 42-450 C
50 ml
3
stock sol. /L .
4 Βα
μφ
MHA
υ
ί
π
μ
μ
ία
α
(μ
) HB + 1ml
-NAD
4 mm +/- 0,5 mm
υ
π φα ία π
υ
α
α
Stock -NAD 20 mg/l
- Β υ
π
ί
μ φί
π
υ
-20 0C
ί π
, pH , α αμ
QC
0.2 μm
μ
π
Χ 1
μ
μ
α
α α
- 12.
- 13.
- 15.
- 16.
Β υ
α
(EUCAST version3.0 April 2013)
π
υ
ί
υ
π
α ία απ φ
αφυ α
υ ία
Θ μ
α ία
Stock -20 0C
μφ α μ
ί
υ α α
υα
Βα μ
<8 0C
Χ
μα : μ
π α
35 ± 10C α μ. υ
υ
μ
ία
ί
X 16-20 h
35 ± 10C CO2 4-6% Χ 16-20 h
(MH)
(MH-F)
- 17.
- 18.
Β υ
α
(EUCAST version3.0 April 2013)
α
α
μ
Proteus
Ό α
Streptococus spp.
Ό α
Ό
πυ μ
α α
α
π
Trim/sulfom
α
Staphylococcus
spp.
Linezolid
Vancomycin
Ampicillin
E.coli
Mecillinam
Staphylococci
Benzylpenicillin
Staphylococci
Cefoxitin
μ
ί
Transmitted light
Enterobacteriacea
e
π υ
υ
Transmitted light
Enterococcus spp.
αμ
π
α
(
μ μ
μ
Ό α
π υ
μ
π υ φαί α α
πα ί
MH)
απ
μ
α
Transmitted light
α
μ
α
α α
-
- 19.
- 20.
α
ί
παί
υ
Β
υ
(Eucast)
E. coli ATCC25922
S. aureus ATCC 29213
Χ 3 μ
4
P. aeruginosa ATCC 27853
E. faecalis ATCC 29212
4
Χ 3 μ
α α αφ
π
υ
μ
παί υ
υ υ
π
π
(μ .
π υ ,
απ
μα α QC)
H. influenzae NCTC 8468
S. pneumoniae ATCC 49619
Χ 3 μ
4
- 21.
α μ
μπ
α
μ Eucast
DiskDiffusion (September 2013)
α
ία
Βα
μ
α Βί
Βα
μ
υ
Ό α
Abtek
α π
BD
ceftibuten
30μg
α
Bio-Rad
α
α
bioMerieux
12a
α
Liofilchem
α
Mast Group
α
Thermo Fisher
Scientific (Oxoid)
α
α
/π
μ
-NAD
supplement
α
α
(neo- sensitabs)
Rosco
α
ί
α MH-F
α
,
πα
α απ
Eucast
- 22.
α μ
α α
υα
DiskDiffusion υ μα α
α α
υα
α
μ Eucast
μα α (Sept.2013)
υ
α /
μα
xpert
rules
NAI
.α
BioRad
OSIRIS
/ADAGIO
NAI
Giles Scientific
BIOMIC V3
NAI
NAI
I2a
SIRSCAN
2000
2000
automatic
Micro
NAI
ε ≤
NAI
.α
α
α
,
πα
α απ
Eucast
R>
-
- 23.
α μ
Βα αμ
α
α α
υ
μ
ία
bioMerieux
Liofilchem
υα
α
α
μ Eucast
(Sept. 2013)
α
Validated MH-F
ί
2:1
Amoxicillinclavulanate
Ampicillinsulbactam
Amox, amox/cla, ampi, ampi/sulb,
benzylpe. cefaclor, cefota, ceftr,
cefuro, dori, erta,
imi, mero, chlora, clinda, ery, levo,
moxi, oflo, tetra, T/S, vanco
+
Cefep, cefixime, cefpo, cephalo,
cipro, clari, doxy, minocy, rifa, teico
2:1
Amoxicillinclavulanate
Ampicillinsulbactam
Fixed
Thermo
Fisher
Scientific
(Oxoid)
α
Amox, amox/cla, ampi, oxa, cefota,
cefta, ceftaroline, levo, amika, teico,
vanco, ery, tetra, tigecycline
α
,
πα
α απ
Eucast
2:1
Amoxicillinclavulanate
- 24.
π
Θ
π
μ
MIC ααί
α
μ
(EUCAST version 3.0 April 2013)
υ
MHB & MHB- F
50% lysed Horse Blood
- NAD ≥ 98% α α
α
- 25.
α μ
αυ μα
μ
α
μ
Phoenix
ία
Eucast
Software
Eucast
π
μαα
Expert rules
πα
Eucast
Microscan
Sept.2013
Vitek 2
S ≤ √
R >
√
IE √
S ≤
R >
IE
√
√
√
√
S ≤ √
R > α αμ
α αμ
IE α αμ
S ≤
R >
IE
S ≤ √
R > √
√
IE
S ≤ √
R > α αμ
√
√
√
√
NAI
-
IE
OXI
OXI
Amp/sulb
(4mg/l fixed sulb)
μα (+)
Eucast (-)
Rif (staphylococcus)
Trim (entero/cus)
Cotrim (entero/cus)
α
α αμ
α αμ
α α ί
NAI
Eucast (+)
μα (-)
α
α
,
πα
trim, chlora, fuc,
rifa, amp/sulb,
amox/clav,
anaerobes
ΗΗΗΗΗ
roxi, teli, doxy,
tige (G+)
ΗΗΗ.
α απ
Eucast
α
α
α
α
α
α
- 26.
π
α
μμα
α
α ί α
1.
υ
αα
αφ Ο
αία
2.
μ
πα
πα
(
,
μ
ία
υ α
,πα
μ
π
υ
α
ία μ α
α π
4.
Χ
μ
α π
3.
α μ
α υ πα
μμα
μπ
, π
π
μ
μ
)
/ υ
πα
(WHONET)
5. Χ
α
α
α
/Θ
/ υ
πα
:
πα
υ
7.
αφ
π
πίπ
6.
απ υ
φα μ
μ
μ
CLSI
ί α μ
α π α
υπα
- 27.